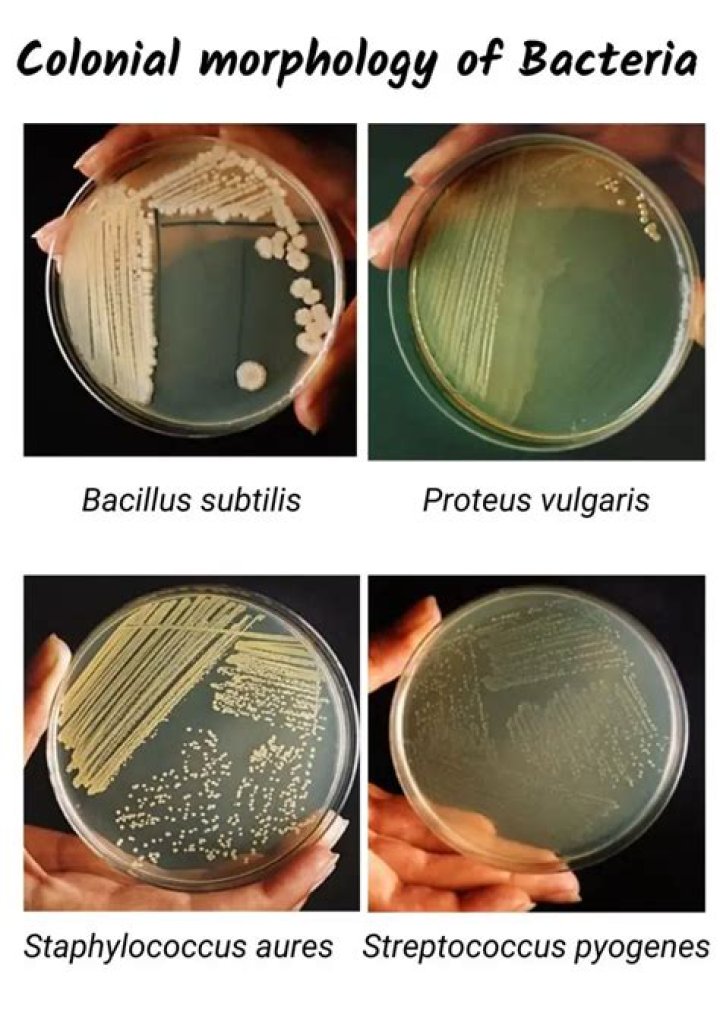

Which is a bacterial colony?
Bacterial Colony Definition and Overview A bacterial colony is what you call a group of bacteria derived from the same mother cell. This means that a single mother cell reproduces to make a group of genetically identical cells, and this group of cells form a mass, which is known as a bacterial colony.
What is a typical bacterial colony?
Each distinct colony represents an individual bacterial cell or group that has divided repeatedly. Being kept in one place, the resulting cells have accumulated to form a visible patch. Most bacterial colonies appear white or a creamy yellow in colour, and are fairly circular in shape.
How do you identify a bacterial colony?
Different types of bacteria produce different-looking colonies, some colonies may be colored, some colonies are circular in shape, and others are irregular. A colony's characteristics (shape, size, pigmentation, etc.) are termed the colony morphology. Colony morphology is the way scientists identify bacteria.
What are 4 examples of bacteria?
Examples include Listeria monocytogenes, Pesudomonas maltophilia, Thiobacillus novellus, Staphylococcus aureus, Streptococcus pyrogenes, Streptococcus pneumoniae, Escherichia coli, and Clostridium kluyveri.
What is a single bacteria colony?
Single Colony Isolation of Bacteria
It is necessary to separate individual bacterial cells from one another on an agar surface in order to produce pure colonies. A colony of bacteria is made up of millions of identical bacterial cells, each originating from one single cell.
Bacterial Colony Description
45 related questions foundIs a colony of bacteria unicellular or multicellular?
Some single-celled organisms such as bacteria can group together and form a colony. A colony refers to a group of individual organisms of the same species that live closely together.
What are mucoid colonies?
mu·coid col·o·ny. a colony showing viscous or sticky growth typical of an organism producing large quantities of a carbohydrate capsule.
What are 5 examples of bacteria?
Top Ten Bacteria- Deinococcus radiodurans.
- Myxococcus xanthus. ...
- Yersinia pestis. ...
- Escherichia coli. ...
- Salmonella typhimurium. ...
- Epulopiscium spp. The big boy of the kingdom – about as large as this full stop. ...
- Pseudomonas syringae. Dreaming of a white Christmas? ...
- Carsonella ruddii. Possessor of the smallest bacterial genome known, C. ...
What are the 3 main types of bacteria?
Most bacteria come in one of three basic shapes: coccus, rod or bacillus, and spiral.
What are the 6 types of bacteria?
Bacteria are classified into five groups according to their basic shapes: spherical (cocci), rod (bacilli), spiral (spirilla), comma (vibrios) or corkscrew (spirochaetes). They can exist as single cells, in pairs, chains or clusters. Bacteria are found in every habitat on Earth: soil, rock, oceans and even arctic snow.
What are some examples of a colony?
An example of a colony was Massachusetts under British rule during the 17th and 18th centuries. An example of a colony is a group of ants. The British colonies that became the original 13 states of the United States.
What type of bacteria is yellow?
Staphylococcus aureus is a very common microorganism that may be responsible for skin and other infections; its name already stresses the “golden-yellow” colour that is conferred to the colonies by zeaxanthin, a yellow-orange pigment belonging to the carotenoids family.
What type of bacteria is orange?
Serratia marcescens (/səˈreɪʃiə mɑːrˈsɛsɪnz/) is a species of rod-shaped, Gram-negative bacteria in the family Yersiniaceae. It is a facultative anaerobe and an opportunistic pathogen. It was discovered in 1819 by Bartolomeo Bizio in Padua, Italy.
How many types of bacterial colonies are there?
Nine obviously different colonies are numbered: some colony types recur in various areas of the plate (note # 3 and # 4). Not only are pigment differences seen, but also size, edge, pattern, opacity, and shine.
What are bacterial colonies and how are they formed?
A bacterial colony is a visible grouping of many bacterial cells that originated from a single parent cell. Therefore, a bacterial colony forms when one bacterial cell divides to form a multitude of clonal cells.
Is E coli a bacillus?
E coli is a gram-negative bacillus that grows well on commonly used media. It is lactose-fermenting and beta-hemolytic on blood agar. Most E coli strains are nonpigmented.
What is the most common type of bacteria?
The following is a comprehensive list of 25 of the most common bacteria and viruses causing HAIs:- Escherichia coli. ...
- Klebsiella pneumoniae. ...
- Morganella morganii. ...
- Mycobacterium abscessus. ...
- Psuedomonas aeruginosa. ...
- Staphylococcus aureus. ...
- Stenotrophomonas maltophilia. ...
- Mycobacterium tuberculosis.
What are the 3 ways bacteria reproduce?
There are 3 ways bacteria reproduce sexually, these are:- Transformation.
- Transduction.
- Conjugation.
What are the common bacteria?
The bacteria and viruses that cause the most illnesses, hospitalizations, or deaths in the United States are described below and include:- Campylobacter.
- Clostridium perfringens.
- E. coli.
- Listeria.
- Norovirus.
- Salmonella.
What is bacterial structure?
Bacteria are prokaryotes, lacking well-defined nuclei and membrane-bound organelles, and with chromosomes composed of a single closed DNA circle. ... They come in many shapes and sizes, from minute spheres, cylinders and spiral threads, to flagellated rods, and filamentous chains.
What are examples of bacterial kingdom?
Examples of protobacteria include the photosynthetic purple bacteria, Pseudomonas, and bacteria that dwell in the intestinal tract of warm-blooded animals (e.g., Escherichia coli , Salmonella, and Shigella. The second eubacterial kingdom is comprised of the Gram-positive bacteria.
How many type of bacteria are there?
How Many Named Species of Bacteria are There? There are about 30,000 formally named species that are in pure culture and for which the physiology has been investigated.
What are mucoid bacteria?
Mucoid Pseudomonas aeruginosa is an im- portant respiratory pathogen in patients with cystic fibro- sis, and once acquired is virtually impossible to eradicate. Although mucoid P.
Which organisms have mucoid colonies?
Pseudomonas aeruginosa isolates usually appear as non-mucoid colonies when cultured on agar media, but respiratory isolates from patients with cystic fibrosis (CF) characteristically produce mucoid colonies (Fig. 4.1).
What is the mucoid?
(Entry 1 of 2) 1 : resembling mucus. 2 : forming large moist sticky colonies —used of dissociated strains of bacteria.



